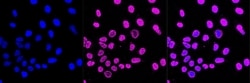
Invitrogen DDB1 Recombinant Rabbit Monoclonal Antibody (23GB2265), Invitrogen

missing translation for 'onlineSavingsMsg'
Learn More
Learn More
Invitrogen™ DDB1 Recombinant Rabbit Monoclonal Antibody (23GB2265), Invitrogen™
Rabbit Recombinant Monoclonal Antibody
Brand: Invitrogen™ MA553257
This item is not returnable.
View return policy
Description
The DNA damage-binding protein from HeLa cells is associated with polypeptides of relative mass 124,000 (DDB1) and 41,000 (DDB2) as determined by SDS-polyacrylamide gels. To test whether the DNA-repair defect in the subset of XPE patients that lack DNA damage-binding activity is caused by a defect in DDB, Keeney et al. (1994) injected purified human DDB protein into XPE cells.
Specifications
| DDB1 | |
| Recombinant Monoclonal | |
| 0.32 mg/mL | |
| PBS with 50% glycerol and 0.02% sodium azide; pH 7.4 | |
| Q16531, Q3U1J4, Q9ESW0 | |
| DDB1 | |
| A synthesized peptide derived from human DDB1 (1100-1140AA). | |
| 20 μL | |
| Primary | |
| Human, Mouse, Rat | |
| Antibody | |
| IgG |
| Flow Cytometry, Western Blot, Immunocytochemistry | |
| 23GB2265 | |
| Unconjugated | |
| DDB1 | |
| 127kDa; AA408517; damage specific DNA binding protein 1; damaged-DNA recognition protein 1; damage-specific DNA binding protein 1, 127kDa; damage-specific DNA-binding protein 1; damage-specific DNA-binding protein, DNA repair; DDB p127 subunit; DDB1; DDBa; DNA damage-binding protein 1; DNA damage-binding protein a; DNA repair protein; HBV X-associated protein 1; p127-Ddb1; UV-damaged DNA-binding factor; UV-damaged DNA-binding protein 1; UV-DDB 1; UV-DDB1; XAP1; XAP-1; xeroderma pigmento; Xeroderma pigmentosum group E-complementing protein; XPCE; XPE; XPE-BF; XPE-binding factor | |
| Rabbit | |
| Affinity chromatography | |
| RUO | |
| 13194, 1642, 64470 | |
| -20°C | |
| Liquid |
Product Content Correction
Your input is important to us. Please complete this form to provide feedback related to the content on this product.
Product Title
Spot an opportunity for improvement?Share a Content Correction